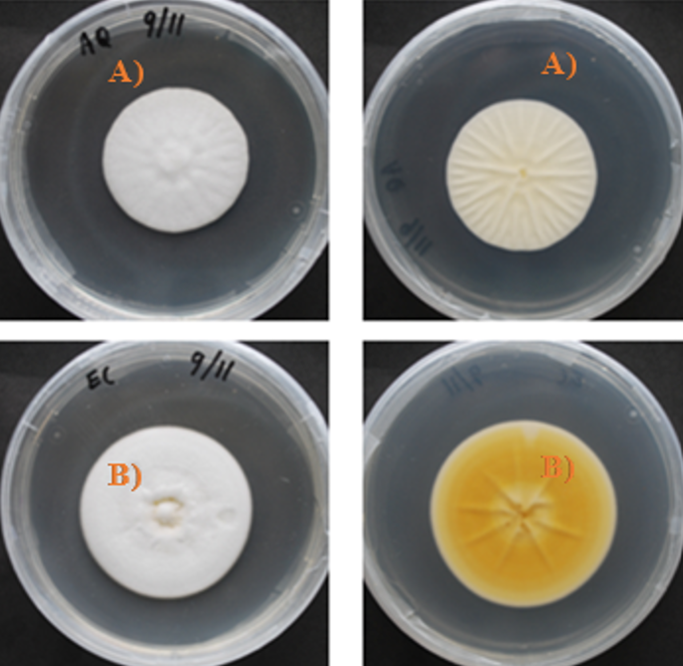

Introducción
El cultivo de café enfrenta múltiples enfermedades, siendo la roya del café (Hemileia vastatrix) una de las más significativas económicamente. Esta enfermedad causa caída prematura de hojas y secado de ramas, lo que puede resultar en una pérdida superior al 50% de la cosecha e incluso la muerte de las plantas (Aristizábal y Johnson, 2022).
El brote de roya más devastador en Centroamérica ocurrió durante el ciclo 2012-2013, con pérdidas estimadas que superó los 499 millones de dólares, lo que llevó a varios países a declarar una emergencia nacional (Promecafé, 2013; IICA, 2013). Los métodos de control habituales para esta enfermedad incluyen el uso exclusivo de fungicidas convencionales o protectores a base de cobre, sin embargo, estos tienen efectos que pueden afectar la composición microbiana del suelo, alterando las funciones y procesos bioquímicos que ocurren en él, lo que también, provocó que las plantas sean más susceptibles a las enfermedades (Meena et al., 2020). Como alternativa, se pueden implementar técnicas de manejo sostenible mediante el uso de enemigos naturales de H. vastatrix asociados a la roya del café (García-Nevárez et al., 2019).
Anteriormente, el hongo micoparásito Lecanicillium lecanii (Zimmerman) (Guharay et al., 2001), se reportó como controlador biológico de H. vastatrix (Santiago-Elena et al., 2020). Este micoparásito ataca cuando la roya está activa (dentro del tejido vivo del huésped) introduciendo su tubo germinativo en las membranas celulares, para posteriormente producir metabolitos que inhiben la germinación, afectan la morfología de las uredosporas y provocan la muerte del hongo (Moricca y Ragazzi, 2008).
Debido a lo anterior, al aislar hongos parásitos de la roya, se asume que el hongo aislado es Lecanicillium (Verticillium), sin mayor evidencia que sustente su identificación. Esta suposición puede ser riesgosa, especialmente cuando se inician nuevos protocolos de investigación. La inclusión de nuevos hongos aislados asociados al control natural de plagas o enfermedades requiere una correcta identificación antes de establecer experimentos enfocados a un programa de control biológico y es fundamental para una producción de bioplaguicidas de calidad (Safavi, 2010).
Este proceso debe ser realizado por taxónomos especializados mediante la identificación por características morfológicas como son la forma, tamaño y velocidad de germinación de los conidios, así como la apariencia de la colonia (forma, elevación, apariencia superficial y color) (Hajek y Leger, 1994) y requiere el uso de marcadores moleculares, para su adecuada identificación. La identificación molecular por amplificación del espaciador transcrito interno Internal Transcribed Spacer (ITS), por sus siglas en inglés ofrece resultados rápidos y fiables para la mayoría de los taxones de hongos, por lo que actualmente se considera una de las principales herramientas de diagnóstico (Lücking et al., 2020).
El objetivo del estudio fue realizar una caracterización cultural, fisiológica e identificación molecular de cepas fúngicas asociadas a pústulas de H. vastatrix en la zona cafetalera de Turrialba, Costa Rica.
Materiales y métodos
El estudio incluyó cinco cepas fúngicas de la zona cafetalera de Turrialba, Cartago, Costa Rica en las comunidades de San Juan Norte (SJ), Jabillos (JV), Aquiáres (AQ), Santa Rosa (SR) y CATIE (EC) donde los cafetos se ubicaron entre 600 y 950 msnm. Las muestras fueron hojas de café con lesiones avanzadas de roya y hongos creciendo sobre esta (Figura 1).
Aislamiento de cepas. Se realizaron sembrando el inóculo en placas con medio papa dextrosa agar (PDA), este inoculo se obtuvo de las pústulas que presentaban un crecimiento algodonoso sobre ellas.
Caracterización macroscópica. Se realizaron aislamientos monosporicos de 10 colonias por cepa mediante diluciones (10-4, 10-5 y 10-6), estas se sembraron e incubaron 25-28 °C, durante 15 días a 25-28 °C para después registrar el color (Munsell Color Company 1988) y la forma, elevación y estriado formado según los criterios propuestos por Fox (1999).
Identificación molecular
Se realizó la extracción del material genético según el protocolo descrito por Kuske et al. (1998), seguido de una amplificación de la región ITS utilizando los iniciadores ITS1 (5’-TCCGTAGGTGAACCTGCGG-3’) e ITS4 (5’-TCCTCCGCTTATTGATATGC-3’) mediante reacción en cadena de la polimerasa Polymerase Chain Reaction (PCR), por sus siglas en inglés, el producto obtenido de la amplificación fue visualizado en un gel de agarosa al 1% para su posterior secuenciación. El consenso de las secuencias se realizó con el programa BioEdit y se compararon con las reportadas en la base de datos del National Center for Biotechnology Information (NCBI) mediante la herramienta Blast.
Caracterización microscópica
Se determinó el tamaño de muestra necesario para medir el tamaño de los conidios midiendo grupos con distintos números de conidios y calculando la desviación estándar (DE) en cada caso. Se seleccionó el tamaño de muestra que garantizara una DE estable (Cortez et al., 2003). Basado en estos resultados, se realizaron mediciones en cinco repeticiones de colonias monospóricas de cada cepa. En cada repetición, se midieron cuatro grupos de conidios, observando 35 conidios por grupo, utilizando una cámara Omax ToupView® x 86 montada en un microscopio compuesto previamente calibrado.
Crecimiento radial y producción de conidios
Se utilizó la técnica de dilución seriada para aislar cada cepa monospórica y cultivarlas en PDA en cajas Petri. Tras 10 días de incubación a 25-28 °C, se midió el diámetro radial promedio con un vernier digital Truper® Caldi-6 MP. Para evaluar la producción de conidios, se suspendió un cm² de cada cepa en 10 ml de agua destilada estéril con Tween 80 al 0.1%, se sometió a un baño ultrasónico durante tres minutos y se agitó en un vortex por un minuto. Los conidios se contaron con una cámara de Neubauer. Se realizaron mediciones del crecimiento radial y conteos de conidios en 10 colonias por cepa.
Análisis estadístico
El experimento se llevó a cabo mediante un diseño completamente al azar, con 10 repeticiones de cada colonia para evaluar el crecimiento radial y cinco para evaluar el tamaño de conidios. El análisis se realizó utilizando modelos generales lineales y mixtos con el paquete estadístico InfoStat. Para las variables de número y tamaño de conidios se utilizó la prueba de separación de medias DGC (p= 0.05) con el fin de eliminar la falta de carácter transitivo entre medias y facilitar la discusión de los resultados. Para la variable crecimiento radial se realizó la prueba LSD (p≤ 0.05).
Resultados
Caracterización macroscópica. La diferencia más notable entre cepas fue el cambio de color al fondo de la caja Petri. Las cepas JV y SR exhibieron un color amarillo oliva, mientras que EC, AQ y SJ presentaron colores amarillo, blanco y amarillo pálido, respectivamente. El color blanco del micelio fue consistente entre todas las cepas, así como la forma circular y el borde elevado. Solo AQ mostró abundantes estrías en el medio de cultivo durante el crecimiento (Cuadro 1), que en ocasiones se podía apreciar desde la parte superior de la colonia (Figura 2).
Cuadro 1 Morfología colonial de cepas de hongos asociados a pústulas de Hemileia vastatrix.
| Cepa | Color arriba/abajo | Notación Munsell | Forma | Borde | Relieve | Formación de estrías |
|---|---|---|---|---|---|---|
| EC | Blanco/amarillo | 2.5Y 7/8 | Circular | Completo | Elevada | Baja |
| AQ | Blanco/blanco | 5Y 8/2 | Circular | Completo | Elevada | Abundante |
| JV | Blanco/amarillo oliva | 2.5Y 6/6 | Circular | Completo | Elevada | Baja |
| SR | Blanco/amarillo oliva | 2.5Y 6/6 | Circular | Completo | Elevada | Baja |
| SJ | Blanco/amarillo pálido | 2.5Y 8/4 | Circular | Completo | Elevada | Baja |
SR= cepa de Santa Rosa; AQ= Aquiáres; CE= CATIE; JV= Jabillos; SJ= San Juan Norte.
El tamaño de los conidios fue significativamente diferente entre cepas (p≤ 0.003). Las cepas EC, AQ y JV, que tuvieron un tamaño de 1.97, 1.94 y 1.88 µm, respectivamente, fueron estadísticamente iguales (DGC= 0.05), pero con diferencia significativa respecto a SR (1.75 µm) y SJ (1.73 µm) (Figura 3).

Figura 3 Tamaño de conidios (µm) de cepas de Simplicillium sp. Medias con la misma letra son estadísticamente iguales (p≥ 0.05) (DGC= 0.05). CE= cepa CATIE; AQ= Aquiáres; JV= Jabillos; SR= Santa Rosa; SJ= San Juan Norte.
Caracterización microscópica. La división del género Verticillium realizada por Zare y Gams (2004) se basa en estudios sistemáticos, separa los taxones formados por fiálides solitarias del género Lecanicillium y los ubica dentro del género Simplicillium. Desde esta perspectiva, las características microscópicas de las cepas evaluadas coinciden con las de este último género. También se observaron conidios ovalados (1.7 a 1.97 µm) dentro de cabezas globosas que estaban suspendidas de fiálides solitarias y a veces, postradas (Figura 4).
Crecimiento radial y producción de conidios. Hubo una diferencia altamente significativa entre las cepas con respecto al crecimiento radial después de cinco y diez días de crecimiento en PDA (p˂ 0.0001). Las cepas que presentaron mayor crecimiento a los cinco días fueron SJ y EC con 18.9 y 18.39 mm, respectivamente, mientras que SR, AQ y JV mostraron los menores valores con 16.44, 15.67 y 15.65 mm, respectivamente y no difirieron estadísticamente entre sí (p≥ 0.05). Después de 10 días, los mayores valores de crecimiento los obtuvieron las cepas SJ (36.1 mm) y EC (33.5 mm), seguidas de AQ (28.8 mm), mientras que SR (26.8 mm) y JV (25.7 mm) presentaron los menores valores. Estos resultados indican una gran variabilidad dentro del mismo género (Figura 5).

Figura 5 Crecimiento radial (mm) de cepas de Simplicillium sp. Medias con la misma letra no difieren estadísticamente (LSD= 0,05). SJ= cepa de San Juan Norte; CE= CATIE; SR= Santa Rosa; AQ= Aquiáres; JV= Jabillos.
La producción de conidios varió significativamente entre las cepas (p˂ 0.0001). Las cepas SJ, JV y SR mostraron una mayor producción con valores de 1.4×107, 1.3×107 y 1.2×107 cm-2, a su vez las cepas SR y SJ presentaron el tamaño de conidios más pequeño (1 75 y 1.73 µm). Por el contrario, se registró que las cepas EC y AQ disponían estructuras más grandes (1.97 y 1.94 µm, respectivamente); sin embargo, produjeron significativamente menos= EC produjo 6.8×10 6 conidios cm-2 y AQ 4.4×106 conidios cm-2 valores no difirieron estadísticamente entre sí (p≥ 0.05) (Figura 6).

Figura. 6 Producción de conidios de cepas Simplicillium sp. Medias misma letra son estadísticamente iguales (DGC= 0.05). SJ= cepa de San Juan Norte; JV= Jabillos; SR= Santa Rosa; CE= CATIE; AQ= Aquiáres.
Identificación molecular. Las cepas EC, AQ, SR, SJ y JV aisladas y analizadas en la base de datos del NCBI coincidieron con la especie Simplicillium lanosoniveum. Las secuencias para cada cepa identificada se seleccionaron para ser registradas en la base de datos NCBI GeneBank (Cuadro 2).
Cuadro 2 Especies identificadas y número de acceso generado en el NCBI, en base a porcentajes de similitud.
| Cepa | Organismos | Núm. de acceso de NCBI |
|---|---|---|
| CATIE (CE) | Simplicillium lanosoniveum | OQ325474 |
| Aquiáres (AQ) | Simplicillium lanosoniveum | OQ325475 |
| Santa Rosa (SR) | Simplicillium lanosoniveum | OQ325476 |
| San Juan Norte (SJ) | Simplicillium lanosoniveum | OQ325477 |
| Jabillos (JV) | Simplicillium lanosoniveum | OQ325478 |
Discusión
Los resultados de este estudio contrastan con otras publicaciones que involucran el control biológico natural (CBN) de H. vastatrix en la misma región de Costa Rica. Esta diferencia se debe principalmente a que publicaciones anteriores señalan al hongo L. lecanii como el principal enemigo natural de la roya del café (Vandermeer et al., 2009; Jackson et al., 2012), mientras que, en la presente investigación, las cepas analizadas correspondieron Simplicillium lanosoniveum. La incorrecta determinación del controlador natural de H. vastatrix puede ser causado por la apariencia similar del hongo mientras parasita a la roya, tanto Simplicillium como Lecanicillium forman una capa algodonosa blanca. Además, estos géneros comparten características morfológicas, lo que muchas veces conduce a una clasificación incorrecta (Lim et al., 2014).
La característica cultural con mayor variación entre cepas fue el color de las colonias visto desde el fondo de la caja Petri. Una explicación para esto podría ser la formación de estructuras de resistencia sumergidas en el medio de cultivo, aspecto descrito por Inderbitzin et al. (2011) en especies de Verticillium. Luego de 15 días de crecimiento, se observó que las cepas JV y SR tienden a formar estructuras de resistencia en menor tiempo, ya que el color del micelio sumergido cambió de blanco a amarillo oliva (2.5Y 6/6 en la escala de Munsell) durante la incubación; observaciones similares fueron regristradas por Cortez et al. (2003) sobre aislamientos de Lecanicillium.
La tendencia de las cepas a crear estructuras de resistencia en un menor tiempo puede ser consecuencia de un menor crecimiento radial, como se observa en nuestros resultados que muestran que las cepas JV y SR presentaron los valores de crecimiento más bajos (Figura 5). Además, los cambios de color en el medio de cultivo pueden asociarse a la capacidad de la cepa para producir metabolitos secundarios (VanderMolen et al., 2013).
Dado que la información sobre la capacidad de Simplicillium para producir conidios es muy limitada en este momento, se pueden realizar comparaciones con taxones relacionados como Verticillium o Lecanicillium.James et al. (2016) encontraron una alta diversidad de hongos mediante análisis molecular en discos de hojas de café infectados por roya. Con base en las comparaciones de discos foliares sin presencia de roya, los autores asumieron que había 15 posibles hongos micoparásitos.
Sin embargo, no se realizaron pruebas de efectividad para examinar si estos hongos realmente tenían algún grado de control sobre H. vastatrix. En un estudio realizado en zonas cafetaleras de Veracruz, México, Gómez et al. (2017) aislaron hongos micoparásitos de pústulas de roya y encontraron un hongo del género Simplicillium con altas propiedades de control biológico. En un estudio reciente realizado por Si et al. (2022) registraron a S. lanosoniveum como un nuevo hiperparásito de la roya del trigo Puccinia graminis, a pesar de tratarse de diferente cultivo esta investigación también confirma que este hongo está asociado al control biológico de royas.











 texto en
texto en